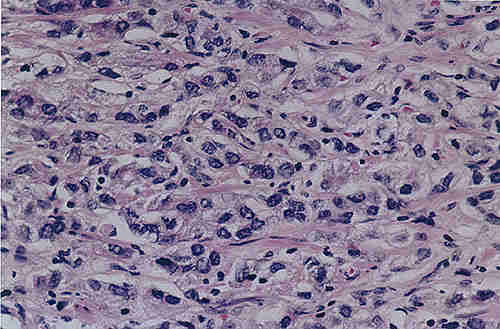

|
Understanding Gleason GradingIntroduction | The five Gleason grades | The combined Gleason score or Gleason sum | What does the Gleason score mean? IntroductionPhysicians
use the term "grade" to describe the appearance of thin slices of cancer
tissue when it is observed under a microscope. In the case of prostate
cancer tissue, the most common system used in the USA to grade the appearance
of this tissue is called the Gleason grading system, after the physician
who first described this system.
The Gleason grading system is not the only grading system in use around the world. However, because it is the one most commonly used in the USA, it is the one we will try to explain here. If your physician talks to you about the grade of your prostate cancer, you may want to ask if it is the Gleason grade that he or she is referring to. The Gleason grade is one of several pieces of information determined by the pathologist who examines the biopsy specimen taken from the prostate. Readers wishing to understand more about the role of the pathologist in the diagnosis of prostate cancer may wish to read the article entitled "The pathologic examination of prostate tissue", which addresses this topic in detail, and which also explains the importance to the patient of receiving a copy of his pathology report. The Gleason system is based exclusively on the architectural pattern of the glands of the prostate tumor. It evaluates how effectively the cells of any particular cancer are able to structure themselves into glands resembling those of the normal prostate. The ability of a tumor to mimic normal gland architecture is called its differentiation, and experience has shown that a tumor whose structure is nearly normal (well differentiated) will probably have a biological behavior relatively close to normal -- that is not very aggressively malignant. The principle is fairly simple, and Gleason grading from very well differentiated (grade 1) to very poorly differentiated (grade 5) is usually done for the most part by viewing the low magnification microscopic image of the cancer. There are important additional details which require higher magnification, and an ability to accurately grade any tumor is achieved only through much training and experience in pathology.
The five Gleason gradesDr. Gleason has provided a conceptual diagram (oversimplified)
in Figure 1 to show the continuum of deteriorating cancer cell architecture,
and the four dividing lines along this continuum which he discovered
are able to identify patients with significantly different prognosis
derived from a study which included 2,900 patients.
In the illustrations and text that follow, we have given real examples of tissues which show the five Gleason grades and tried to describe the differences between them. We would like to thank Dr John McNeal of the Department of Urology, Stanford University School of Medicine, for kindly providing these illustrations and assisting us in developing this information.
 Figure 2: Grade 1 (left) and grade 2 (right) protate adenocarcinoma. Both have pale cells and well formed, separate glands with lumens. Grade 1 is more compact (less invasive) than grade 2. Illustration courtesy of John E. McNeal, MD, Department of Urology, Stanford University School of Medicine.
The combined Gleason score or Gleason sumWhen a pathologist looks at prostate cancer specimens
under the microscope and gives them a Gleason grade, he or she in fact
will always try to identify two architectural patterns and assign
a Gleason grade to each one. There may be a primary or most common pattern
and then a secondary or second most common pattern which the pathologist
will seek to describe for each specimen; alternatively, there may often
be only a single pure grade.
In developing his system, Dr Gleason discovered that by giving a combination of the grades of the two most common patterns he could see in any particular patient's specimens, he was better able to predict the likelihood that that particular patient would do well or badly. Therefore, even though it may seem confusing, the Gleason score which a physician usually gives to a patient is actually a combination or sum of two numbers. These combined Gleason sums or scores may be determined as follows:
What does the Gleason score mean?The grade of a prostate cancer specimen is very valuable
to doctors in helping them to understand how a particular case of prostate
cancer can be treated. In general, the time for which a patient is likely
to survive following a diagnosis of prostate cancer is related to the
Gleason score. The lower the Gleason score, the better the patient is
likely to do.
However, remember that prostate cancer is a very complicated disease. People with low Gleason scores have been known to fare poorly and men with high Gleason scores have been known to do well. General principles do not always apply to individual patients. By combining the patient's Gleason score with his PSA level and the clinical stage estimated by the physician, it is possible to use the Partin coefficient tables to estimate the likelihood that that patient has localized or locally advanced prostate cancer of different types.
|
This posting and overall website maintenance by
Anthony Cancio
|
|
|